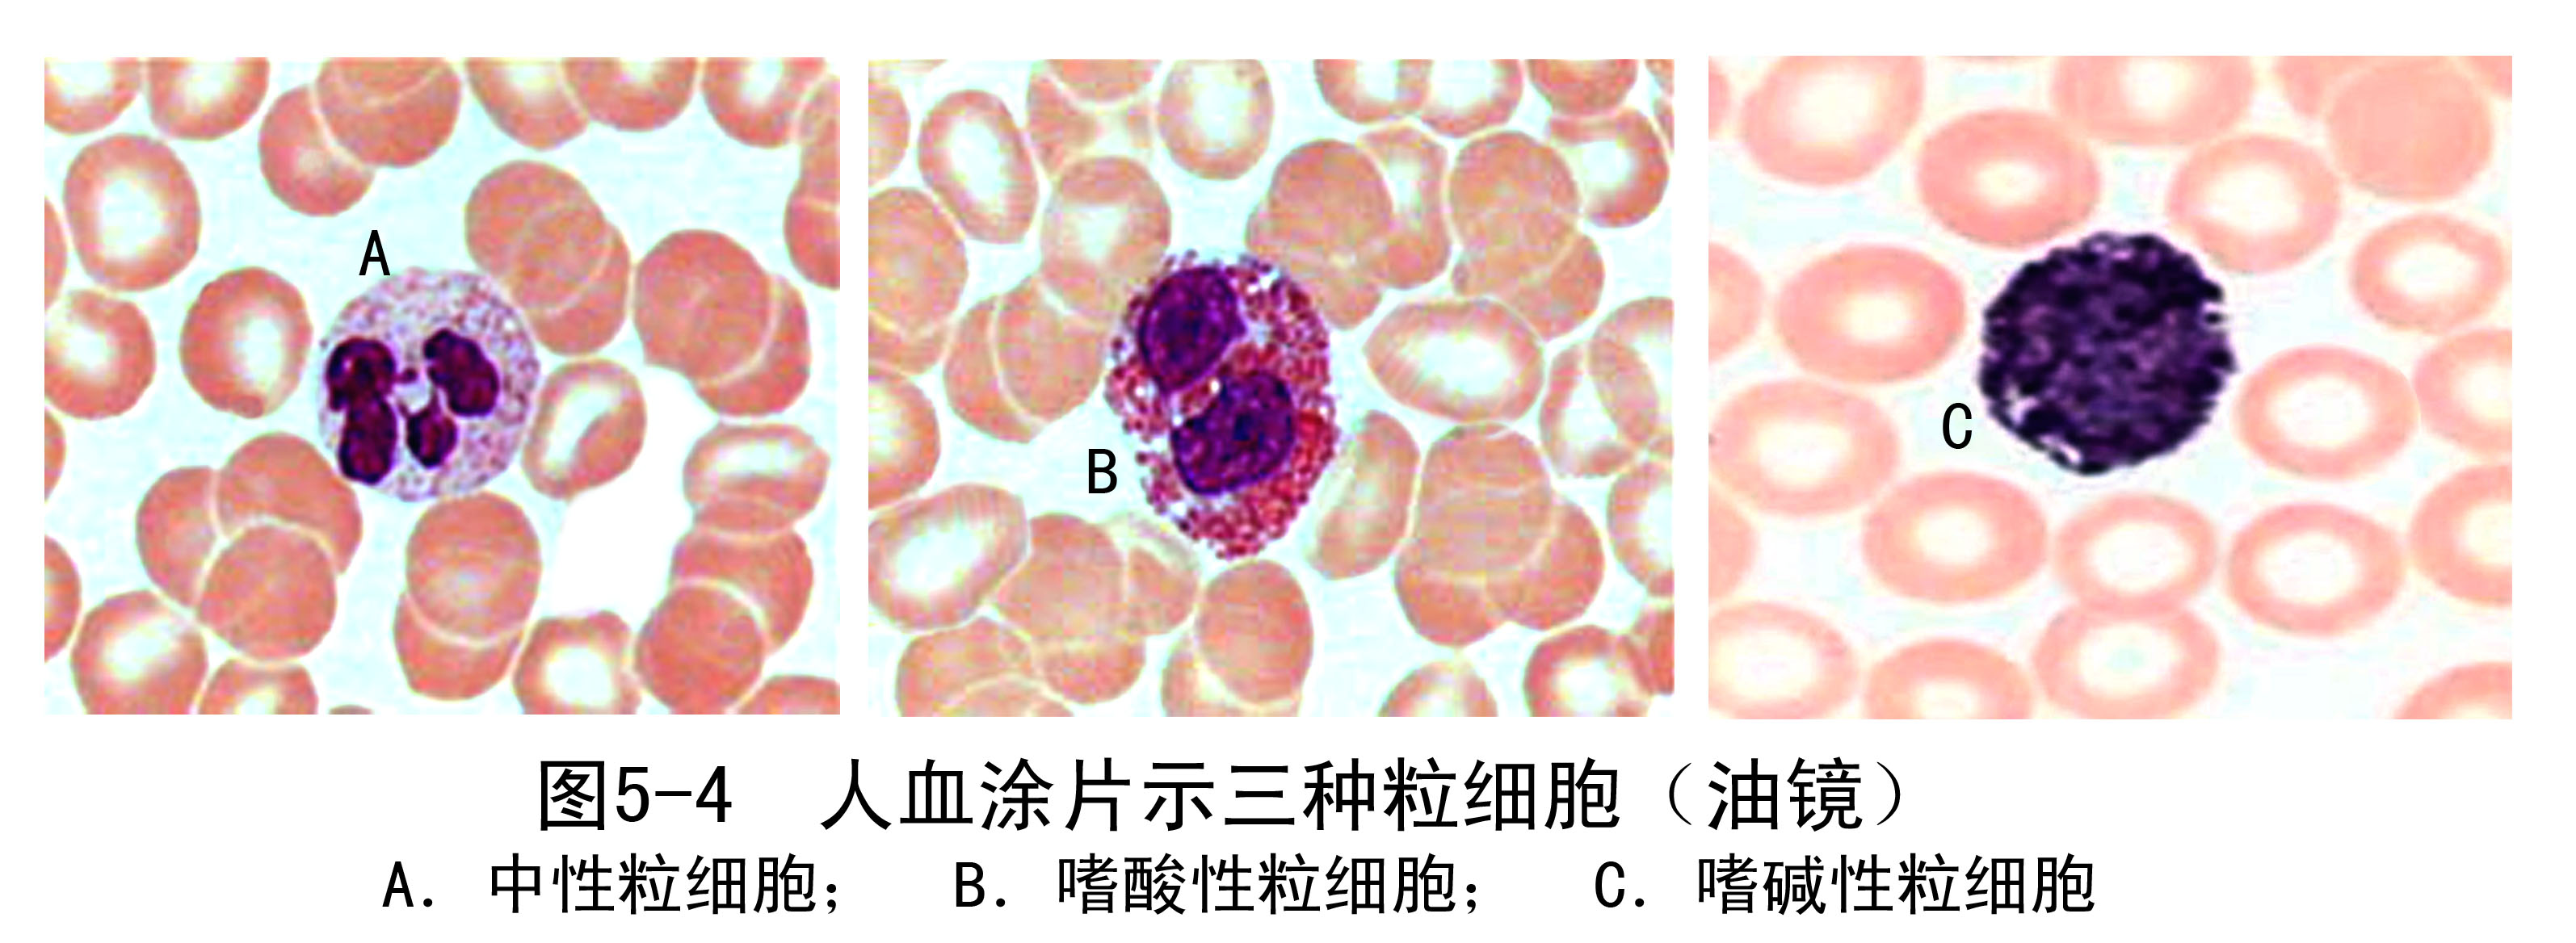
图5-4.jpg
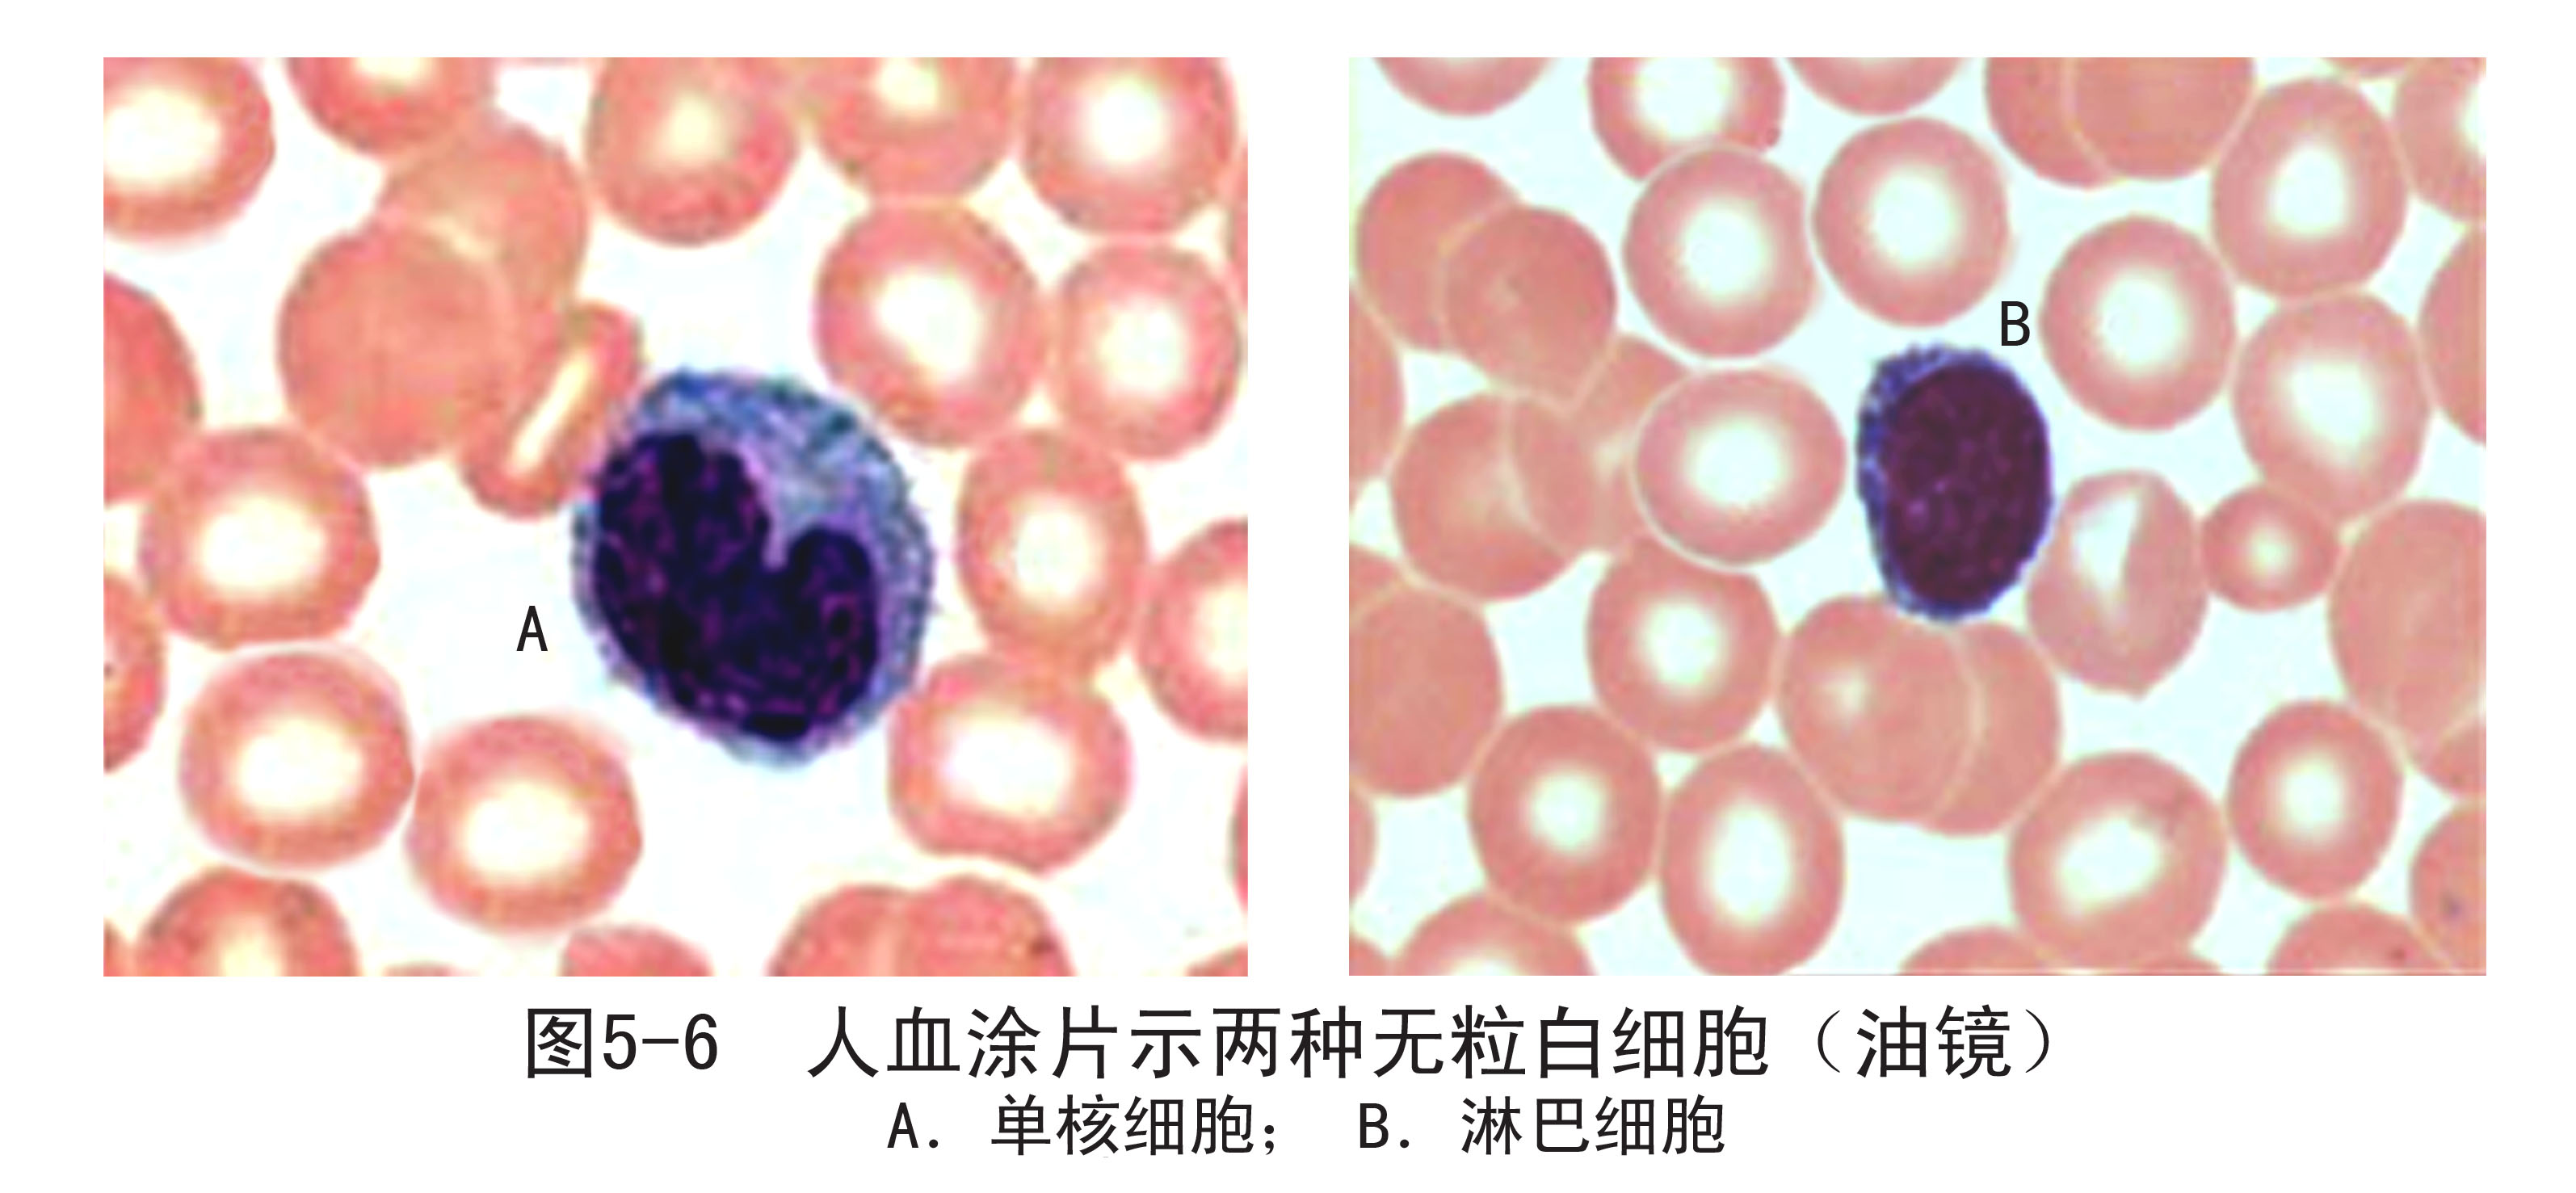
图5-6.jpg

白细胞(leukocyte,whiteblood cell)是有核的球形细胞,由骨髓生成进入血液后一般于24小时内以变形运动方式穿过微血管壁,进入周围组织,发挥其防御和免疫功能。血液中白细胞的数值可受各种生理及病理因素的影响。根据白细胞胞质内有无特殊颗粒,可将其分为有粒白细胞和无粒白细胞。前者常简称粒细胞,根据其特殊颗粒的染色特性,又可分为中性粒细胞、嗜碱性粒细胞和嗜酸性粒细胞三种;后者则有单核细胞和淋巴细胞两种,均含有细小的嗜天青颗粒。
1.中性粒细胞
中性粒细胞(neutrophilic granulocyte,neutrophil)是数量最多的白细胞。细胞呈球形,直径10~12μm,胞核呈杆状或分叶状,分叶核一般为2~5叶,叶间有细丝相连,正常人以2~3叶者居多。若杆状核与2叶核的细胞增多,称为核左移,常出现在机体受细菌严重感染时;若4~5叶核的细胞增多,称为核右移,表明骨髓的造血功能发生障碍
中性粒细胞的胞质呈极浅的粉红色,含有许多细小颗粒,其中浅紫色的为嗜天青颗粒(azurophilic granule),浅红色的为特殊颗粒(specific granule)。嗜天青颗粒约占颗粒总数的20%,电镜下颗粒较大,直径0.6~0.7μm,呈圆形或椭圆形,电子密度较高。它是一种溶酶体,含有酸性磷酸酶、髓过氧化物酶和多种酸性水解酶类等,能消化吞噬的细菌和异物。特殊颗粒约占颗粒总数的80%,电镜下颗粒较小,直径0.3~0.4μm,呈哑铃形或椭圆形(图5-4、5)。特殊颗粒是一种分泌颗粒,内含溶菌酶、吞噬素(phagocytin)等,吞噬素也称防御素(defensin),具有杀菌作用。
中性粒细胞具有很强的趋化作用和吞噬功能,其吞噬对象以细菌为主,也吞噬异物。中性粒细胞在吞噬、处理了大量细菌后,自身也死亡,成为脓细胞。中性粒细胞从骨髓进入血液,约停留6~8小时,然后离开,在结缔组织中存活2~3天。

2.嗜碱性粒细胞
嗜碱性粒细胞(basophilic granulocyte,basophil)数量最少,直径10~12μm。核分叶,或呈S形或不规则形,着色较浅。胞质内含有嗜碱性颗粒,大小不等,分布不均,染成蓝紫色,可将核掩盖。电镜下,嗜碱性颗粒内充满细小微粒,呈均匀状或螺纹状分布(图5-4、5)。嗜碱性颗粒属于分泌颗粒,内含有肝素、组胺、嗜酸性粒细胞趋化因子等;细胞基质内有白三烯。显然,嗜碱性粒细胞与肥大细胞的分泌物相同,也参与过敏反应。嗜碱性粒细胞在组织中可存活10~15天。
3.嗜酸性粒细胞
嗜酸性粒细胞(eosinophilic granulocyte,eosinophil)直径为10~15μm,核常为两叶,胞质内充满粗大的鲜红色嗜酸性颗粒,直径约0.5~1.0μm。电镜下,可见颗粒内基质中有长方形结晶体(图5-4、5)。嗜酸性粒细胞是一种特殊的溶酶体,除含一般溶酶体酶外,还含有组胺酶、芳基硫酸酯酶以及阳离子蛋白。
嗜酸性粒细胞也能作变形运动,穿过毛细血管到病变部位,吞噬抗原抗体复合物,释放组胺酶灭活组胺,从而减轻过敏反应。嗜酸性粒细胞释放的阳离子蛋白,对寄生虫有很强的杀灭作用。当患过敏性疾病或寄生虫病时,血液中嗜酸性粒细胞增多。嗜酸性粒细胞在血液中一般仅停留6~8小时,在结缔组织中可存活 8~12天。
4.单核细胞
单核细胞(monocyte)是体积最大的白细胞,直径为 14~20μm。核呈肾形、马蹄形或扭曲折叠的不规则形,染色质颗粒细而松散,故着色较浅。胞质丰富,呈弱嗜碱性,胞质内含有许多细小分散的嗜天青颗粒,使胞质染成深浅不均的灰蓝色。电镜下,细胞表面有少许短的微绒毛,胞质内有许多吞噬泡、线粒体和粗面内质网,嗜天青颗粒相当于溶酶体(图5-6、7)。单核细胞在血流中停留12~48小时,然后进入结缔组织,分化成巨噬细胞。机体内大多数具有吞噬能力的细胞均来源于单核细胞。它除了具有吞噬和杀菌功能之外,还能清除体内衰老和损伤的细胞,并参与免疫作用。

5.淋巴细胞
淋巴细胞(lymphocyte)呈圆形或椭圆形,大小不等,可分为大、中、小三种。血液中的淋巴细胞大部分为直径 6~8μm的小淋巴细胞,小部分为直径9~12μm的中淋巴细胞。在淋巴组织中还有直径13~20μm的大淋巴细胞,但不存在于血液中。小淋巴细胞的核为圆形,一侧常有浅凹,染色质浓密呈块状,着色深。中淋巴细胞的核染色质略稀疏,着色略浅,有的可见核仁。淋巴细胞的胞质为较强的嗜碱性,呈晴空样蔚蓝色。小淋巴细胞的胞质很少,在核周形成很薄的一圈,中淋巴细胞胞质较多;胞质中可含嗜天青颗粒。电镜下,淋巴细胞胞质含大量游离核糖体以及溶酶体、粗面内质网、高尔基复合体和线粒体等(图5-6、7)。
淋巴细胞不仅产生于骨髓,而且产生于淋巴器官和淋巴组织。根据淋巴细胞的发生来源、形态特点和免疫功能等方面的不同,可分为三类:
(1)胸腺依赖淋巴细胞(thymus dependent lymphocyte):简称T细胞,产生于胸腺,在血液淋巴细胞中约占总数的75%;其体积小,胞质内含少量溶酶体;它参与细胞免疫,如排斥异体移植物、抗肿瘤等,并具有免疫调节功能。
(2)骨髓依赖淋巴细胞(bone marrow dependent lymphocyte):简称B细胞,产生于骨髓,约占10%~15%;其体积略大,一般不含溶酶体,有少量粗面内质网;B细胞受抗原刺激后增殖分化为浆细胞,产生抗体,参与体液免疫。
(3)自然杀伤细胞(nature killer cell):简称NK细胞,产生于骨髓,约占10%;为中淋巴细胞,溶酶体较多。
淋巴细胞是主要的免疫细胞,在机体防御疾病过程中发挥关键作用。

